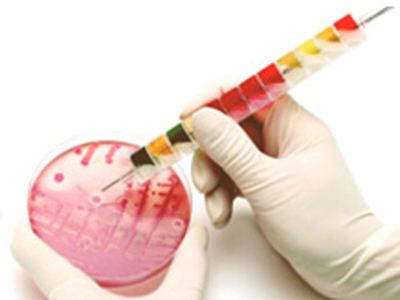

Enteropluri Test 25 Tst/Bx Ident Of Bact ,Each
$ 708.87
|
|
Details:
EnteroPluri-Test 25test^ EnteroPluri-Test, for identification of gram negative bacteria, similar to Enterotube, not for human diagnostic use, 12-sector system containing special culture media that permits identification of the Enterobacteriaceae and oxidase negative bacteria, Size: 25 tests
Additional Information
| SKU | 24006865 |
|---|---|
| UOM | EACH |
| UNSPSC | 41106204 |
| Manufacturer Part Number | 215336 |
| Product Dimensions | 1X1X1 Inches |
| Product Weight | 1.7 |
